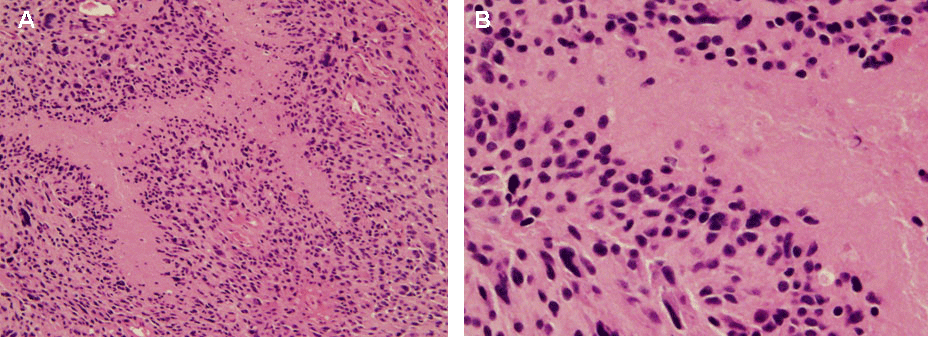

|
| Figure 4: Distinguishing cellular features of GBM. One of the distinguishing features of GBM compared to lower grade gliomas is the extent of tissue necrosis within the tumor mass. H&E stains of tumor tissue at 20X (A) and 40X (B). Pseudopalisading cells surrounding the necrotic foci, a feature suggestive of the poor prognostic nature of GBM, can be observed. |